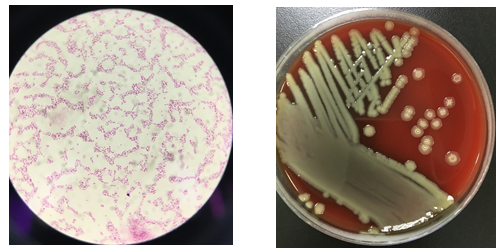

想要成为“上得天堂,下得厨房”的完美煮妇(夫),需要具备什么条件?拥有无可挑剔的厨艺?设施齐全的厨房?新鲜生猛的食材?这些当然都很重要,但还需要知道那些隐藏在角落的“杀手”,保住小命才有资格成为天选煮妇(夫)。一起看看下面的案例你能发现几个厨房里的隐藏“杀手”
案例1:
某个深夜,李女生突发高烧,就医后立即抽血培养送检,居然查出猪链球菌。猪链球菌是一种人畜共患病原菌,在健康猪中的带菌率约42%,广泛存在猪的呼吸道及扁桃体中,一般只引起免疫力低下的新生猪仔或幼猪的感染,且病死率奇高。人主要通过破损皮肤或粘膜接触带菌的猪被感染。人感染该菌后可出现高热、寒战、头痛等症状,严重者可出现败血症和脑膜炎。
追踪病史,李女士前两天徒手处理了生猪肉,恰巧手上有倒刺,且处理完生肉后只是用流水简单洗手。因此,推测李女士感染猪链球菌是由于接触带菌生肉时,细菌经手中倒刺入侵引起感染。
案例2:
老刘家是吃鱼大户,几乎隔天就要吃一顿鱼。这天他照旧去菜市场挑选了几条刚刚上岸的泥猛鱼,没想在家处理鱼的时候,手一滑,左手小拇指不慎被鱼刺中,流了一点血。老刘简单冲洗了一下伤口也没太当回事,接着做美食。
没想到,午休后,受伤的小拇指越来越肿了,而且还伴着剧烈的疼痛。老刘赶紧找出家里的陈年老酒,往伤口上面泼,想用烈酒消消毒。又过了两个小时,伤口非但不见好转,反而越来越红,老刘顿感事态不妙,火速赶往急诊就医。尽管医生积极的救治,老刘还是不幸被截去了一个小拇指,原来他是感染了令人闻风丧胆的创伤弧菌!
图1创伤弧菌显微镜下形态(左图)及菌落特征(右图)
创伤弧菌广泛存在于近海水体、海底淤泥、海产品中,特别是牡蛎、蚌等贝壳类海洋生物,主要通过食用未煮熟的贝壳类海鲜及伤口接触带菌海水或被鱼虾刺伤引起感染。该菌引起的感染,起病急骤、进展快,多在24至48小时内进展为感染性休克和多器官功能不全,被称为“海洋中的无声杀手”。
案例3:
罗阿姨素来热衷养生,小寒刚过,她就想着赶紧炖上一锅美味的羊肉汤驱寒暖身。于是大清早买了两斤羊蝎子回家,没顾上处理刚刚擦破皮的手背,一气呵成麻利处理干净上锅开炖。喝完美味的羊肉汤没见身骨子变硬朗,还发觉得腰越来越不得劲,时不时地痛起来。这可急坏了罗阿姨,想着自己平素注意保健,该不会落下椎间盘突出了吧?赶紧上医院检查,经过一系列的检查,最终锁定是马耳他布鲁菌在捣乱!

图2马耳他布鲁菌显微镜下细小如沙,不易识别(左图为革兰染色,右图为柯氏染色)
布鲁菌主要寄生在牛羊等动物身上,主要通过体表粘膜、消化道(如进食未煮熟牛羊肉等)、呼吸道等入侵人体,引起布鲁菌病,布鲁菌病是一种人畜共患传染病。该病急性期多表现为发热、乏力、肌肉酸痛等,慢性期多表现为关节损伤。由于起病隐匿,临床表现为广泛多样的非特异性临床症状和体征,与其他感染性疾病和非感染性疾病的症状相似,因此常被贴上“易误诊疾病”的标签。
以上案例只是冰山一角,除了文中列举的三种细菌外,还有很多其它细菌(气单胞菌、非结核分枝杆菌等)可能通过直接接触带菌的海产品或家禽等,引起人类感染。
我们应该如何防止感染呢?
1、在正规市场购买合格的家禽等食材;
2、家中常备料理专用手套处理食材;
3、生熟食材分开用专用砧板和刀具,杜绝交叉污染;
4、不食用未熟透的肉类和海产品。
万一在处理食材时不慎受伤,要立即将血挤出,并用流水冲洗,消毒伤口。如果有任何局部皮肤红肿等不适,最好及时就医处理。
参考资料
[1]贝勒和斯科特诊断微生物学
[2]哈里森感染病学
科普指导:深圳市中医院医学检验科 张惠媚、何进才



